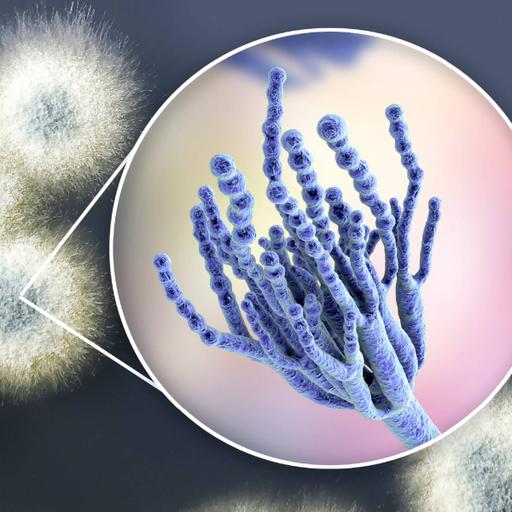
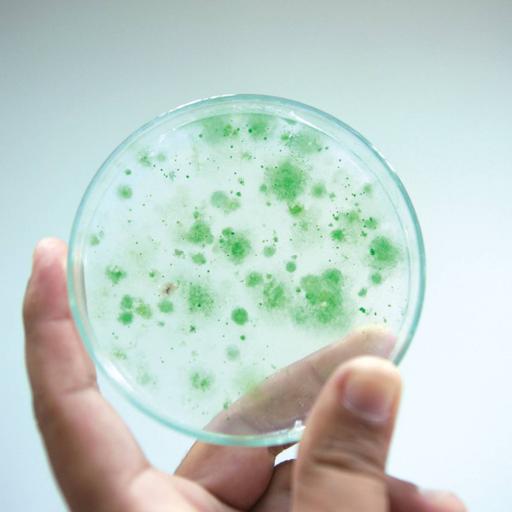
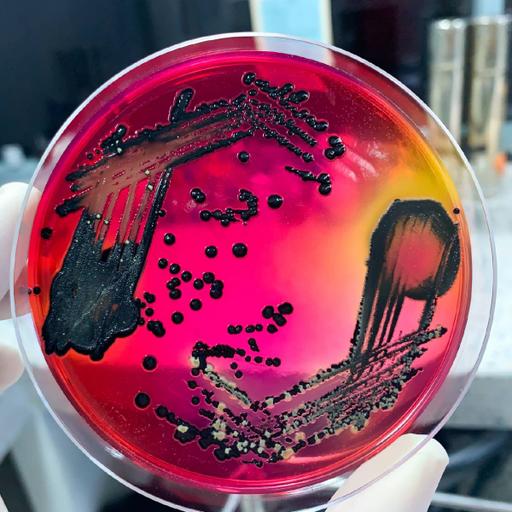

A postgraduate student in Biotechnology has a practical mind and a creative heart. She makes sure she utilises every opportunity that comes her way to express her talents. During her graduation, she learnt about different cultures and people around her. Communication and discipline are two key qualities showcased by her at all times.
View more